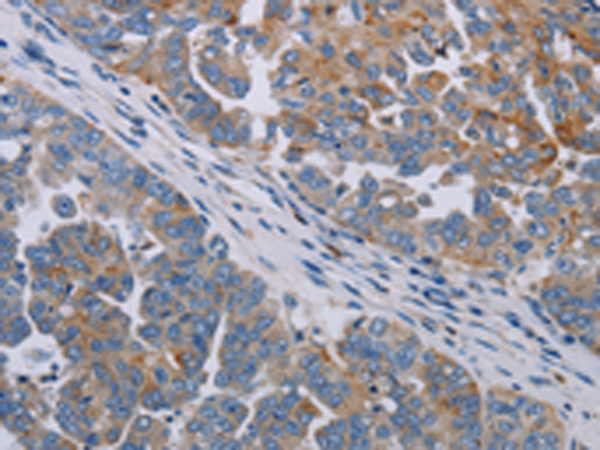

-
分类: 科研抗体货号: P12023别名: ARTD16; pART16应用: IHC反应种属: Human, Mouse
-
分类: 科研抗体货号: P12024别名: ARTD10应用: IHC反应种属: Human
-
分类: 科研抗体货号: P12046别名: PERC; ERRL1; PGC1B; PGC-1(beta)应用: IHC反应种属: Human
-
分类: 科研抗体货号: P12022别名: IRT1; ARTD3; ADPRT3; ADPRTL2; ADPRTL3; PADPRT-3应用: WB,IHC反应种属: Human
-
分类: 科研抗体货号: P12045别名: LEM6; PGC1; PGC1A; PGC-1v; PPARGC1; PGC-1alpha; PGC-1(alpha)应用: IHC反应种属: Human, Mouse, Rat
-
分类: 科研抗体货号: P12021别名: PH5P; p193; ARTD4; PARPL; VPARP; VWA5C; PARP-4; VAULT3; ADPRTL1应用: IHC反应种属: Human
-
分类: 科研抗体货号: P12044别名: PLC; SJA; SJS; HSPG; SJS1; PRCAN应用: IHC反应种属: Human, Mouse
-
分类: 科研抗体货号: P12020别名: PAR3; PAR-3应用: IHC反应种属: Human
-
分类: 科研抗体货号: P12038别名: DLP1; hDLP1; COQ10D3; C6orf210; bA59I9.3应用: WB,IHC反应种属: Human
-
分类: 科研抗体货号: P12054别名: PI3K; PIK3C1; P110BETA; PI3KBETA应用: IHC反应种属: Human, Mouse, Rat

鄂公网安备42018502007531号
鄂公网安备42018502007531号

